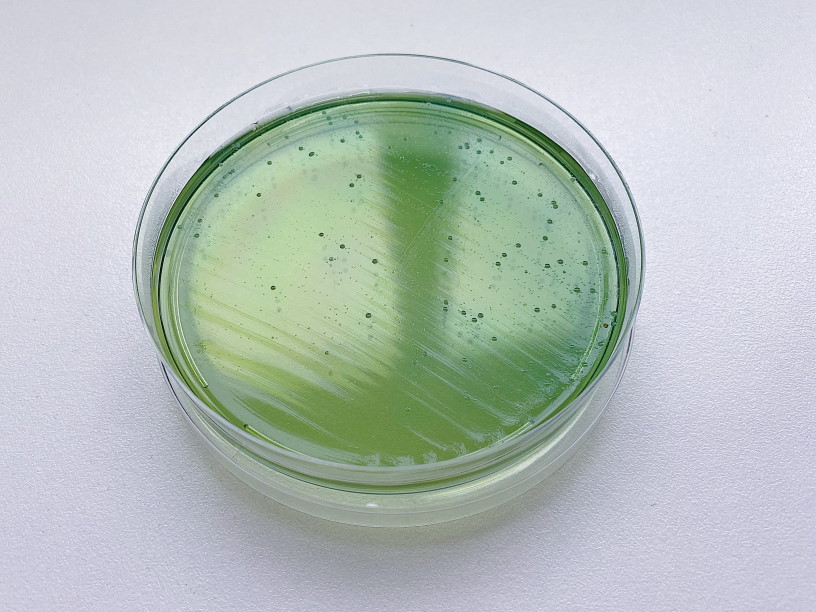

Промикробы: Микротерминатор
Хоть я и работаю в больнице, занимающейся, в основном, плановым лечением и такими же операциями, но наша лаборатория выполняет анализы и для нескольких больниц скорой медицинской помощи. А это совсем другой формат не только лечения, но и микробных агентов. Одним из частых гостей в больницах скорой помощи является ацинетобактер, про него сегодня и поговорим.
⠀
Acinetobacter — род грамотрицательных бактерий из семейства Moraxellaceae. Главная отличительная черта этих крошек — переменчивая форма «тела». Есть бактерии, имеющие форму палочек, есть шарообразные кокки, а эти умеют менять форму, запутывая человека за микроскопом. Обычно они предстают в виде коротких и округлых, но всё-таки палочек, но в стационарной фазе роста приобретают преимущественно форму кокков, располагающихся парами или в виде коротких цепочек. Также можно обнаружить большие клетки непостоянной формы и даже нити.
⠀
Спор ацинетобактеры не образуют, жгутиков не имеют, однако некоторые штаммы на плотной питательной поверхности демонстрируют «дергающуюся» подвижность. Капсулы и фимбрии могут быть, но могут и отсутствовать. Другими словами, трудновато бывает их опознать, по всем пунктам они очень уж переменчивые. Ацинетобактеры являются хемоорганотрофами с окислительным метаболизмом. Способность использовать органические соединения в качестве источников энергии и углерода непостоянна. Строгие аэробы, оптимальная температура для роста 30–32 °С, pH около 7,0. Обычно резистентны к пенициллину.
⠀
Acinetobacter являются свободно живущими сапрофитами, распространены повсеместно. Могут быть причиной многих инфекционных процессов, включая менингиты и септицемии у людей и септицемии и аборты у животных.
В феврале 2017 года ВОЗ причислила ацинетобактеры к наиболее опасным бактериям в связи с их резистентностью к существующим антибактериальным препаратам.
⠀
Acinetobacter baumannii — самый часто встречающийся вид из рода ацинетобактеров. Их естественная среда обитания до сих пор не известна, но в человеческой культуре они ответственны за множество случаев внутрибольничных инфекций. Вызывают менингит, пневмонию, заражение ран, инфекции кровотока и урологические инфекции. Оказывается, они являются проблемой для западных ветеранов Ирака и Афганистана, так как неоднократно приводили к осложнениям при лечении ранений. Из-за последнего обстоятельства бактерию даже иронично прозвали Iraqibacter.
⠀
Оппортунистические заболевания, вызванные Acinetobacter baumannii, могут не отличаться по симптомам от вызванных другими бактериями. Эти малыши не очень опасны для здоровых людей, но, атакуя тех, чей иммунитет снижен, приводят к более серьезным последствиям. А вы сами понимаете, длительное лечение и пребывание в больничных стенах не способствуют усилению сопротивляемости организма. Вот поэтому в больницах скорой помощи, особенно в анестезиолого-реанимационных отделениях, где тяжелые пациенты порой лежат очень долго, ацинетобактеры показывают свой дурной нрав.
⠀
A. baumannii включают в так называемый ESKAPE-патоген (Enterococcus faecium, Staphylococcus aureus, Klebsiella pneumoniae, Acinetobacter baumannii, Pseudomonas aeruginosa и виды из рода Enterobacter) — группу бактерий с повышенной резистентностью к антибиотикам, которые ответственны за большинство больничных инфекций. Поэтому в очередной раз мораль басни такова — разумное применение антибиотиков.